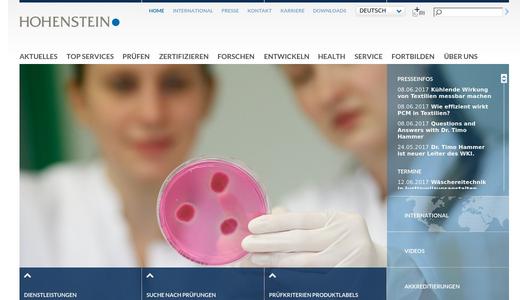
Website Promotion

Wie jedoch lässt sich die kühlende Wirkung von Textilien messen? Hierzu wurden zwar diverse physikalische Methoden entwickelt, diese sind aber bislang nicht mit bekleidungsphysiologischen Methoden und Modellen vergleichbar, die den Komfort objektiv bestimmen und bewerten können. Hilfreich und wünschenswert wäre eine Methode, die sowohl physikalische Messdaten als auch Ergebnisse der Kühlwirkung aus kontrollierten Trageversuchen in einer Klimakammer berücksichtigt. Das allerdings erfordert einen hohen Zeitaufwand und eine große Probandengruppe, was letztlich zu erhöhten Produktpreisen führt. Kurzum: Ein Aufwand, der für KMUs weder finanzierbar noch realisierbar ist.
Messdaten vergleichbar machen
Das Hohenstein Institut für Textilinnovation (HIT) hat mit dem Wärmeabgabetester (WATson) bereits eine neue physikalische Messmethode für die Bestimmung der Kühlleistung von Textilien entwickelt. Jedoch fehlt bislang die Korrelation der mittels WATson erhaltenen Daten zu realen Trageversuchen und bekleidungsphysiologischen Berechnungsmodellen.
Die Textilindustrie jedoch benötigt ein solches Bewertungssystem für die zielgerichtete Entwicklung kühlender Textilien; ein System also, das die Auswirkungen der Kühlung misst, d.h. Temperaturbereich, Dauer, Wirkung auf den Wärme- und Feuchtehaushalt des Menschen.
Auf Basis dieser Anforderungen startet das HIT ein Forschungsvorhaben für die Textilindustrie zur Entwicklung eines bekleidungsphysiologischen Bewertungssystems. Ziel ist es, dass das neue Bewertungssystem die Resultate des Wärmeabgabetesters WATson mit den Daten aus kontrollierten Trageversuchen in der Klimakammer unter Berücksichtigung unterschiedlicher Klimabedingungen in Wechselbeziehung setzt.
Aufbau des Forschungsprojektes
- Charakterisierung von kühlenden Textilien mit dem Wärmeabgabetester WATson
- Durchführung von überwachten Trageversuchen in der Klimakammer unter Berücksichtigung verschiedener kühlender Textilien und verschiedener Umgebungsbedingungen (Temperatur, Feuchte, Wind etc.)
- Untersuchung des Kühleffektes von Textilien unter Berücksichtigung verschiedener Körperregionen
- Untersuchung des Kühleffektes von Textilien bei unterschiedlich hohen körperlichen Belastungen
Nutzen für die Textilindustrie
Die deutschen Hersteller von kühlenden Textilien profitieren unmittelbar von dem in diesem Projekt entwickelten Bewertungsmodell, welches die Kühlleistung von Textilien objektiv bestimmen und bewerten soll. Das vorliegende Projekt hat deshalb für die heimische Textilindustrie einen erheblichen wirtschaftlichen Nutzen, weil die Steigerung der Wettbewerbsfähigkeit nur dann gelingt, wenn die Produkte auch tatsächlich die vom Käufer gewünschte Funktionalität aufweisen.
Danksagung: Das IGF-Vorhaben 18929 N der Forschungsvereinigung Forschungskuratorum Textil e.V., Reinhardtstraße 12-14, 10177 Berlin wurde über die AiF im Rahmen des Programms zur Förderung der industriellen Gemeinschaftsforschung und – entwicklung (IGF) vom Bundesministerium für Wirtschaft und Energie aufgrund eines Beschlusses des Bundestages gefördert.